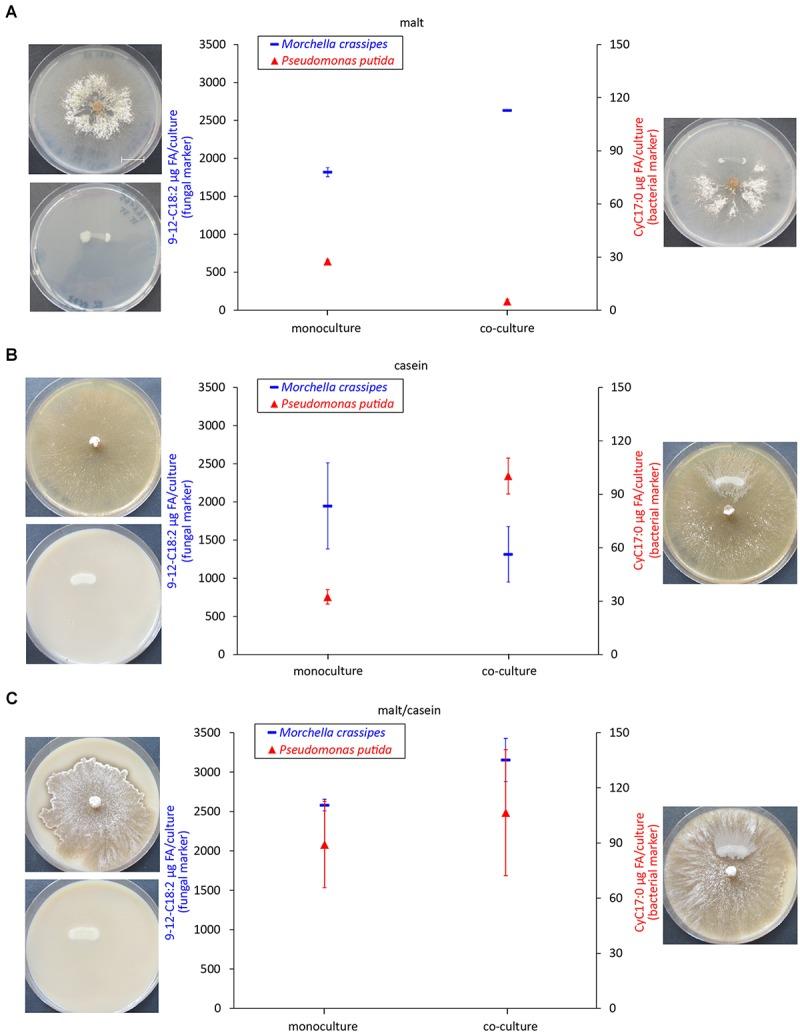

有机碳和氮对 spp. 及其菌丝体上分散细菌相互作用的影响。
Effect of Organic Carbon and Nitrogen on the Interactions of spp. and Bacteria Dispersing on Their Mycelium.
作者信息
Lohberger Andrea, Spangenberg Jorge E, Ventura Yolanda, Bindschedler Saskia, Verrecchia Eric P, Bshary Redouan, Junier Pilar
机构信息
Laboratory of Microbiology, Institute of Biology, University of Neuchâtel, Neuchâtel, Switzerland.
Laboratory of Biogeosciences, Institute of Earth Surface Dynamics, University of Lausanne, Lausanne, Switzerland.
出版信息
Front Microbiol. 2019 Mar 1;10:124. doi: 10.3389/fmicb.2019.00124. eCollection 2019.
In this study we investigated how the source of organic carbon (C) and nitrogen (N) affects the interactions between fungi of the genus and bacteria dispersing along their hyphae (fungal highways; FH). We demonstrated that bacteria using FH increase the hydrolysis of an organic nitrogen source that only the fungus can degrade. Using purified fungal exudates, we found that this increased hydrolysis was due to bacteria enhancing the activity of proteolytic enzymes produced by the fungus. The same effect was shown for various fungal and bacterial strains. The effect of this enhanced proteolytic activity on bacterial and fungal biomass production varied accordingly to the source of C and N provided. An increase in biomass for both partners 5 days post-inoculation was only attained with a N source that the bacterium could not degrade and when additional C was present in the medium. In contrast, all other combinations yielded a decrease on biomass production in the co-cultures compared to individual growth. The coupled cycling of C and N is rarely considered when investigating the role of microbial activity on soil functioning. Our results show that cycling of these two elements can be related through cross-chemical reactions in independent, albeit interacting microbes. In this way, the composition of organic material could greatly alter nutrient turnover due to its effect on the outcome of interactions between fungi and bacteria that disperse on their mycelia.
在本研究中,我们调查了有机碳(C)和氮(N)的来源如何影响与沿着菌丝(真菌高速公路;FH)扩散的细菌之间的相互作用。我们证明,利用FH的细菌会增加一种只有真菌才能降解的有机氮源的水解。使用纯化的真菌分泌物,我们发现这种水解增加是由于细菌增强了真菌产生的蛋白水解酶的活性。各种真菌和细菌菌株都显示出相同的效果。这种增强的蛋白水解活性对细菌和真菌生物量生产的影响因所提供的C和N的来源而异。仅在接种后5天,当细菌无法降解的氮源以及培养基中存在额外的C时,两个伙伴的生物量才会增加。相比之下,与单独生长相比,所有其他组合在共培养中都会导致生物量生产下降。在研究微生物活动对土壤功能的作用时,很少考虑C和N的耦合循环。我们的结果表明,这两种元素的循环可以通过独立但相互作用的微生物中的交叉化学反应联系起来。通过这种方式,有机物质的组成可能会因其对在菌丝体上扩散的真菌和细菌之间相互作用结果的影响而极大地改变养分周转。